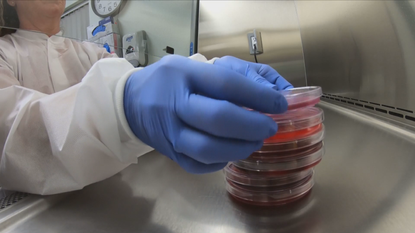

How Much Is Covid Testing In Utah Without Insurance


Many People With Employer Sponsored Insurance Would Face High Out Of Pocket Costs For Covid 19 Treatment Urban Institute
www.urban.org
Wellness Bus Offering No Cost Covid 19 Testing To Those Without Insurance City News Cottonwood Heights Ut
www.cottonwoodheights.utah.gov


/cdn.vox-cdn.com/uploads/chorus_image/image/66752131/merlin_2280265.0.0.jpg)



/cdn.vox-cdn.com/uploads/chorus_image/image/66808738/merlin_2777546.0.jpg)



/cdn.vox-cdn.com/uploads/chorus_image/image/66881198/merlin_2809747.0.jpg)










/cdn.vox-cdn.com/uploads/chorus_image/image/66619955/merlin_2588423.0.jpg)





/https://static.texastribune.org/media/files/c5b054af7994bf84a47fef45468dfc07/El%20Paso%20COVID%20Testing%20JAJ%20TT%2003.jpg)







/arc-anglerfish-arc2-prod-sltrib.s3.amazonaws.com/public/UB22LBFI2NBFHAASYPP4BJFGFI.jpg)


/arc-anglerfish-arc2-prod-sltrib.s3.amazonaws.com/public/4A77Z4AEB5FJFHEAQYB7E3AUKI.jpg)
/cdn.vox-cdn.com/uploads/chorus_image/image/66687412/merlin_2742271.0.jpg)






/https://static.texastribune.org/media/files/fea72002b5f3194dd2fa0cfdc3f8a294/20200801-covid-test-bill-C.jpg)




/arc-anglerfish-arc2-prod-sltrib.s3.amazonaws.com/public/NKXSLZHQRBFE3DXLPUZNG3D4IY.JPG)

/cloudfront-us-east-1.images.arcpublishing.com/sltrib/G3ZBLWNYQFC77EIQ6S7INLUSEI.jpg)












/cdn.vox-cdn.com/uploads/chorus_image/image/66841345/merlin_2776782.0.jpg)




/cloudfront-us-east-1.images.arcpublishing.com/sltrib/N6G56U6V6BBBNOQHVRZNQV4WO4.jpg)
/cloudfront-us-east-1.images.arcpublishing.com/sltrib/DJPU3DMITJCGZHBPIWYLUV4BOY.jpg)
/cloudfront-us-east-1.images.arcpublishing.com/sltrib/FUJ3RIJFVNGDZN4CU6MLVXBGFI.jpg)




/arc-anglerfish-arc2-prod-sltrib.s3.amazonaws.com/public/K5KA3FW7CJB6TPATVRPDA6R3BM.JPG)







